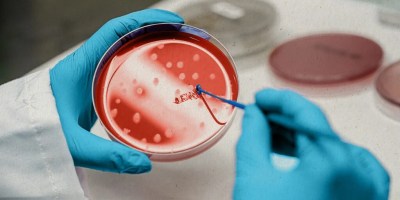

Month: February 2020
12 Posts
Skin Deep Laser MD – Your Ultimate Aesthetic Spa in Fort Worth
What Are the Risk Factors for Atrial Fibrillation?
Professional air ambulance
Are There Any Risks Involved in Getting Braces?
1875: Infographic reveals the year everything changed for drugs
Important Tips for filing Claim with Multiple Insurance Policies